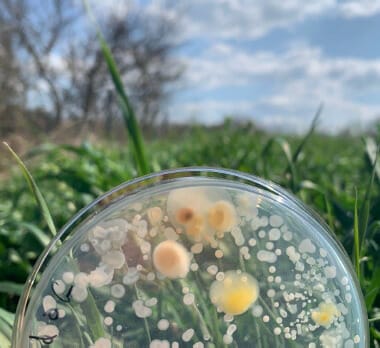
biointrant

BioIntrant en campagne pour l’agriculture durable sur Wiseed
Focus du mois : BioIntrant en campagne pour l’agriculture durable sur Wiseed
BioIntrant, a ouvert une campagne de vote sur la plateforme de financement participatif Wiseed début mai. Si cette étape est concluante, l’entreprise sollicitera une levée de fonds avec un objectif de collecte de 500 000 euros. Cela financera la construction d’une unité industrielle pour permettre la production de plusieurs produits en parallèle et répondre à la demande croissante du marché.
BioIntrant cultive des bactéries phytobénéfiques, à l’instar des probiotiques pour l’homme, afin de protéger les plantes et stimuler leur croissance sans modification génétique. Le marché ciblé par BioIntrant est celui des intrants, aujourd’hui majoritairement chimiques (engrais, pesticides…) utilisés dans l’agriculture. Le marché mondial était estimé en 2019 à 260 milliards d’euros et devrait atteindre 320 milliards d’euros en 2024. BioIntrant se positionne avec des alternatives naturelles.
Ces biosolutions offrent aux agriculteurs la possibilité de restaurer les équilibres biologiques au sein de leurs terres de façon naturelle et durable. Elles sont pertinentes aujourd’hui aussi bien pour des cultures de plein champ que des cultures de spécialité. Disponibles sous forme de poudres, liquides, enrobages de semences, microgranulés, elles ne nécessitent pas de nouveaux matériels ni de nouvelles méthodes de travail. Elles ont déjà donné satisfaction chez des clients et partenaires de BioIntrant où elles sont à l’essai.
BioIntrant est fortement soutenue par les politiques régionales, nationales, et européennes de soutien à l’innovation. L’entreprise a bénéficié d’important investissements financiers, depuis plus de deux ans, de la part de Bpifrance à travers les programmes Frenchtech et Deeptech. Ils ont accéléré la maturation des produits de BioIntrant. Par ailleurs, la communauté européenne dans son programme H2020, a audité et qualifié les produits BioIntrant dans la catégorie « Excellence ».

